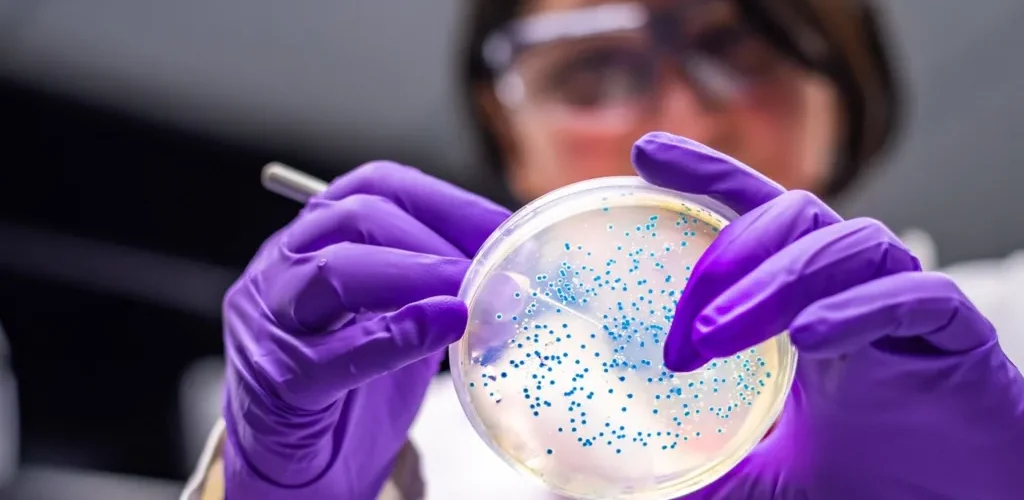
Bakteri që kthen plastikën e përdorur në ilaçe kundër dhimbjes

Në fillim të këtij viti, një mënyrë krejtësisht e pazakontë për të ripërdorur plastikën bëri bujë në media.
Një bakter i zakonshëm u modifikua gjenetikisht për të “ngrënë” një përbërës të nxjerrë nga plastika dhe për ta tretur atë duke prodhuar një nga qetësuesit më të përdorur në botë: paracetamolin, raporton BBC.
Bakteri i përdorur nga profesori i bioteknologjisë kimike në Universitetin e Edinburgut, Stephen Wallace, ishte Escherichia coli, i njohur gjerësisht si E. coli.
Ky bakter në formë shkopi gjendet natyrshëm në zorrët e njerëzve dhe kafshëve. Shumë prej nesh e njohin si një mikrob që mund të shkaktojë probleme të stomakut, por disa lloje të tij që nuk janë patogjenë (pra, nuk shkaktojnë sëmundje), përdoren gjerësisht në laboratorë të bioteknologjisë për të testuar zgjidhje të reja.
“E. coli është mjeti kryesor i kësaj fushe,” thotë profesori Wallace, i cili ka modifikuar gjithashtu këtë bakter për të kthyer mbetjet plastike në aromë vaniljeje dhe mbetjet e zeza nga kanalizimet në parfum.
“Nëse do të provosh diçka të re përmes biologjisë, E. coli është pika më e natyrshme për të filluar,” shton ai.
Përdorimi i E. coli nuk kufizohet vetëm në laboratorë. Në industrinë bioteknologjike, tanke të tëra me këtë bakter të modifikuar shërbejnë si fabrika të gjalla, duke prodhuar gjithçka që nga ilaçet (si insulina, e domosdoshme për menaxhimin e diabetit), deri te kimikatet bazë që përdoren për karburant ose tretës.
Por si arriti E. coli të bëhet një element kaq themelor në bioteknologji? Çfarë e bën kaq të dobishëm dhe çfarë mund të sjellë e ardhmja për të?
Dominimi i E. coli në fushën shkencore lidhet me rolin e tij si një organizëm model, që përdoret për të kuptuar parimet themelore të biologjisë. Profesori Thomas Silhavy, biolog molekular në Universitetin Princeton, që ka studiuar këtë bakter për rreth 50 vjet, e ka dokumentuar gjithë këtë histori.
Organizma të tjerë model përfshijnë minjtë, mizat e frutave dhe tharmën e bukës (maja). Edhe maja, si E. coli, ka luajtur një rol të madh në bioteknologji, por për shkak të ndërtimit më kompleks të qelizave të saj, përdoret për qëllime të tjera.
E. coli u izolua për herë të parë në vitin 1885 nga pediatri gjerman Theodor Escherich, ndërsa studionte mikrobet në zorrët e foshnjave. Falë rritjes së shpejtë dhe lehtësisë në përdorim, shkencëtarët nisën ta përdorin për të studiuar biologjinë bakteriale.
Në vitet 1940, ndodhi një zbulim i rastësishëm (“serendipity”, siç e quan prof. Silhavy): u zbulua se një lloj i padëmshëm i E. coli (K-12) jo vetëm që ndahej përmes riprodhimit, por ishte në gjendje të kryente diçka të ngjashme me “seksin bakterial”, duke shkëmbyer dhe rikombinuar gjene me baktere të tjera për të fituar karakteristika të reja.
Ky zbulim ishte një pikë kthese, dhe E. coli u bë “organismi i preferuar i të gjithëve”, thotë ai.
Pas kësaj, E. coli luajti rol qendror në shumë zbulime dhe përparime në gjenetikë dhe biologji molekulare. Ai ndihmoi në deshifrimin e kodit gjenetik dhe në vitet 1970 u bë organizmi i parë që u modifikua gjenetikisht, kur u fut ADN nga një burim tjetër – duke vendosur themelet e bioteknologjisë moderne.
Nga kafshët te prodhimi i insulinës humane
Një nga sukseset më të mëdha ishte zgjidhja e një problemi me prodhimin e insulinës. Më parë, insulina merrej nga kafshë si lopë dhe derra, por ajo shkaktonte reagime alergjike te disa pacientë.
Në vitin 1978, u prodhua për herë të parë insulina humane sintetike duke përdorur E. coli – një arritje gjigante në mjekësi.
Në vitin 1997, E. coli ishte ndër organizmat e parë që u sekuencua gjenoma e tij plotësisht, duke e bërë shumë më të lehtë për studiuesit ta kuptonin dhe modifikonin.
Pse është kaq praktik në industri?
Profesori Adam Feist nga Universiteti i Kalifornisë në San Diego, i cili punon me mikroorganizma për përdorim industrial, thotë se vlerëson shumë fleksibilitetin e E. coli.
Përveç njohurive të shumta të akumuluara rreth gjenetikës së tij dhe mjeteve të shumta të manipulimit, E. coli rritet shpejt, ushqehet me shumë lloje përbërësish, mund të ngrijë e të ringjallet pa problem, dhe është veçanërisht i mirë në marrjen e ADN-së së huaj.
“Sa më shumë punoj me mikroorganizma të tjerë, aq më shumë e vlerësoj sa i fuqishëm është E. coli,” thotë ai.
Megjithatë, disa studiues pyesin nëse përqendrimi i madh tek E. coli po na pengon të zbulojmë mikrobe më të mira dhe më të natyrshme për zgjidhje të caktuara.
Profesori Paul Jensen, mikrobiolog dhe inxhinier në Universitetin e Miçiganit, që studion bakteret në gojën e njeriut, ka analizuar sa pak janë studiuar bakteret e tjera në krahasim me E. coli.
Ai thotë se ndërkohë që po bëjmë mrekulli me modifikimin e E. coli, mund të ketë mikrobe të tjera që bëjnë këto gjëra në mënyrë natyrale – dhe më mirë – por që po neglizhohen.
“Jemi zhytur aq thellë me E. coli, sa nuk po eksplorojmë mjaftueshëm,” thotë ai.
Për shembull, kërkimi në landfille (deponi) mund të zbulojë mikrobe që kanë filluar të tretin jo vetëm plastikën, por edhe lloje të tjera mbetjesh. Ose mikrobe që prodhojnë çimento, gomë apo substanca të tjera që as nuk i kemi imagjinuar ende. Madje, thotë ai, mikrobet në gojën tonë janë më rezistente ndaj acidit se E. coli.
Disa shkencëtarë po punojnë për alternativa ndaj E. coli – si për shembull Vibrio natriegens (V. nat), një bakter që ka filluar të tërheqë vëmendjen si një konkurrent i mundshëm.
Ky mikrob u izolua për herë të parë në një kënetë me kripë në Gjeorgjinë e SHBA-së, në vitet 1960, por u neglizhua për dekada me radhë. Në mesin e viteve 2010 u rikthye në qendër të vëmendjes për një arsye të fortë: rritet dy herë më shpejt se E. coli, çka përbën një avantazh të madh industrial.
“Është si të kalosh nga kali në makinë,” thotë Buz Barstow, inxhinier biologjik dhe mjedisor në Universitetin Cornell, që po punon për zhvillimin e këtij mikrobi.
Qëllimi i tij është të përdorë mikrobe për të zgjidhur sfida të mëdha të qëndrueshmërisë – që nga prodhimi i karburantit të avionëve nga dioksidi i karbonit e deri te minierat për metale të rralla.
“Thjesht, E. coli nuk mund të na çojë drejt këtyre vizioneve. Vibrio natriegens mundet,” thotë ai.
Laboratori i tij krijoi këtë vit një kompani të re, Forage Evolution, që po punon për të zhvilluar mjete që e bëjnë më të lehtë modifikimin gjenetik të këtij mikrobi.
Profesori Feist e pranon se V. nat ka shumë cilësi tërheqëse, por thekson se ende mungojnë mjetet gjenetike të nevojshme për përdorim të gjerë, dhe se nuk është testuar ende në shkallë të madhe.
“Zëvendësimi i E. coli nuk është gjë e lehtë,” përfundon ai. /BBC/